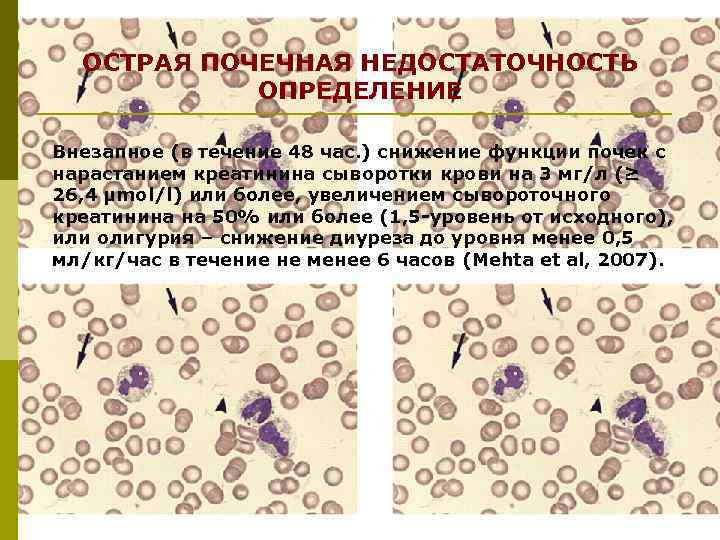
ОСТРАЯ ПОЧЕЧНАЯ НЕДОСТАТОЧНОСТЬ ОПРЕДЕЛЕНИЕ Внезапное (в течение 48 час. ) снижение функции почек с
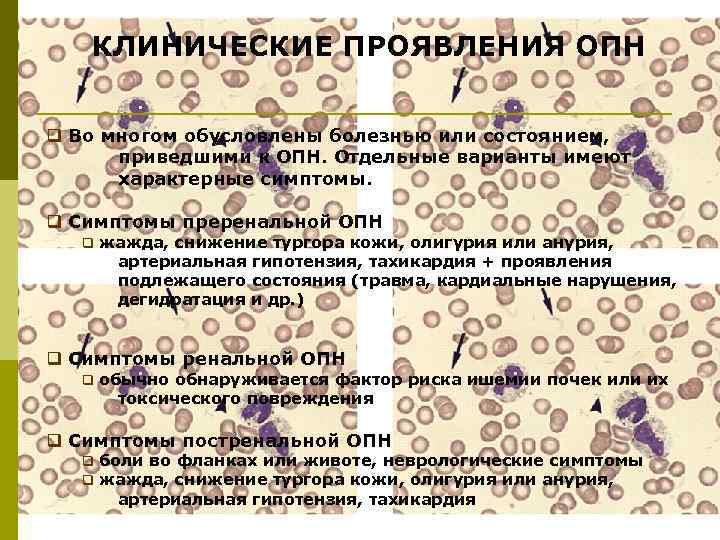
КЛИНИЧЕСКИЕ ПРОЯВЛЕНИЯ ОПН q Во многом обусловлены болезнью или состоянием, приведшими к ОПН. Отдельные
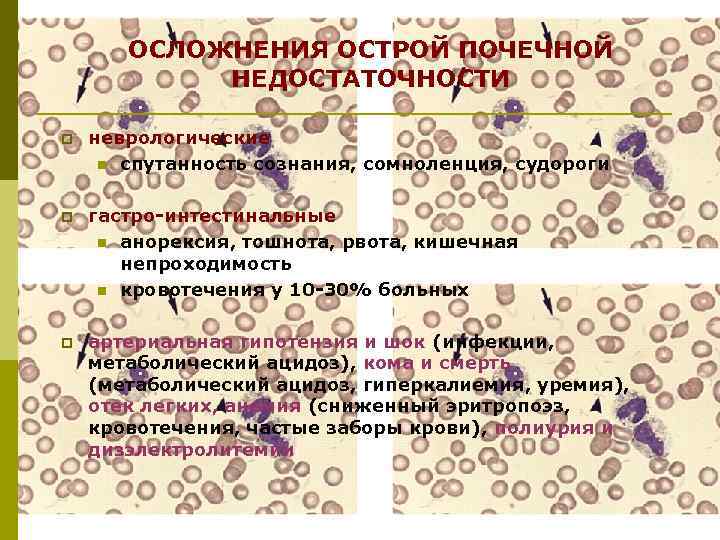
ОСЛОЖНЕНИЯ ОСТРОЙ ПОЧЕЧНОЙ НЕДОСТАТОЧНОСТИ p неврологические n спутанность сознания, сомноленция, судороги p гастро-интестинальные n
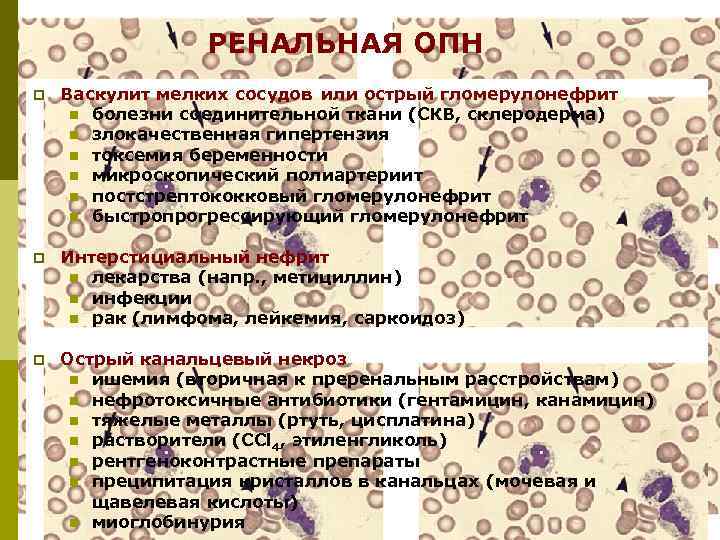
РЕНАЛЬНАЯ ОПН p Васкулит мелких сосудов или острый гломерулонефрит n болезни соединительной ткани (СКВ,
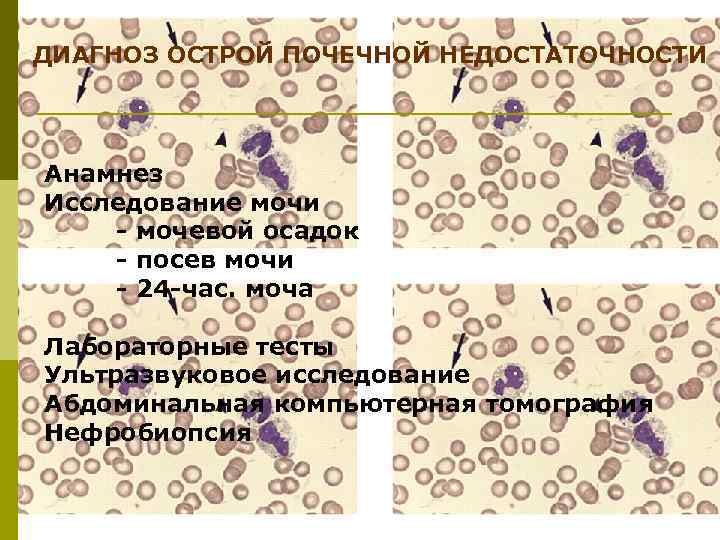
ДИАГНОЗ ОСТРОЙ ПОЧЕЧНОЙ НЕДОСТАТОЧНОСТИ Анамнез Исследование мочи - мочевой осадок - посев мочи -
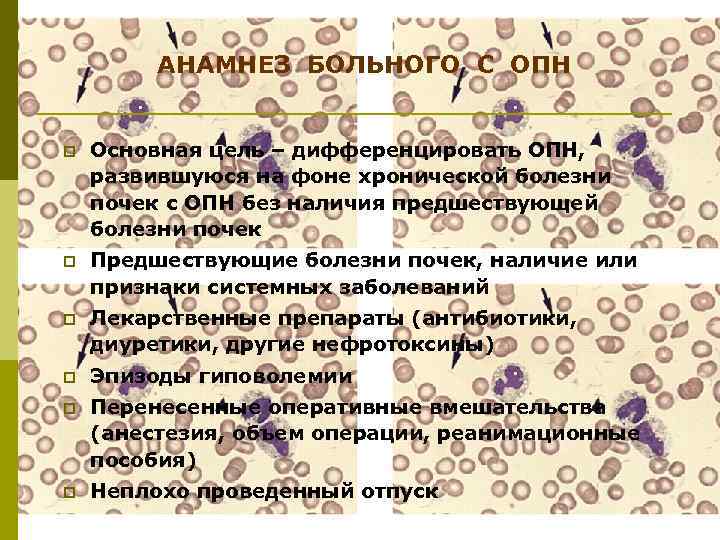
АНАМНЕЗ БОЛЬНОГО С ОПН p Основная цель – дифференцировать ОПН, развившуюся на фоне хронической
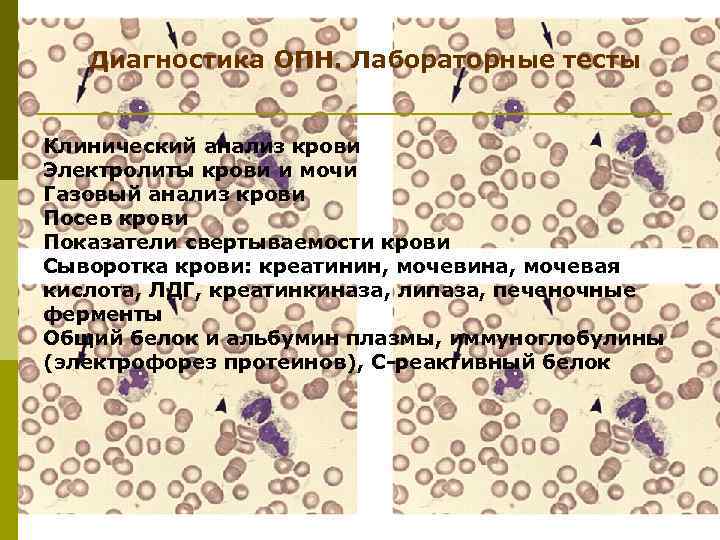
Диагностика ОПН. Лабораторные тесты Клинический анализ крови Электролиты крови и мочи Газовый анализ крови
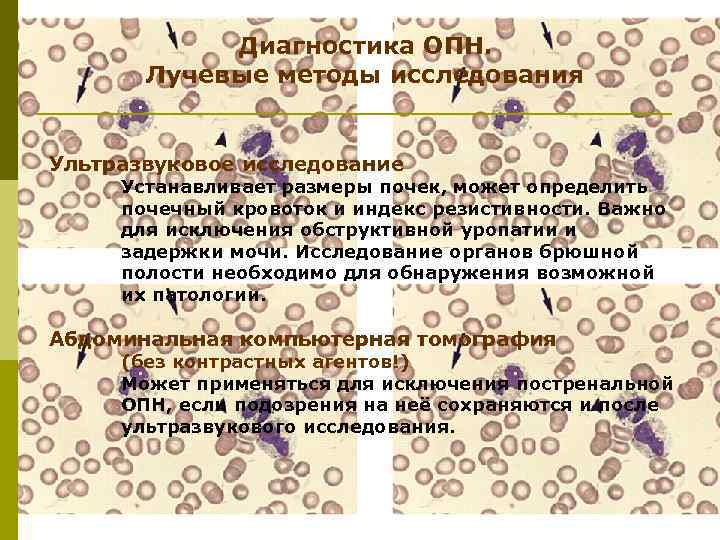
Диагностика ОПН. Лучевые методы исследования Ультразвуковое исследование Устанавливает размеры почек, может определить почечный кровоток
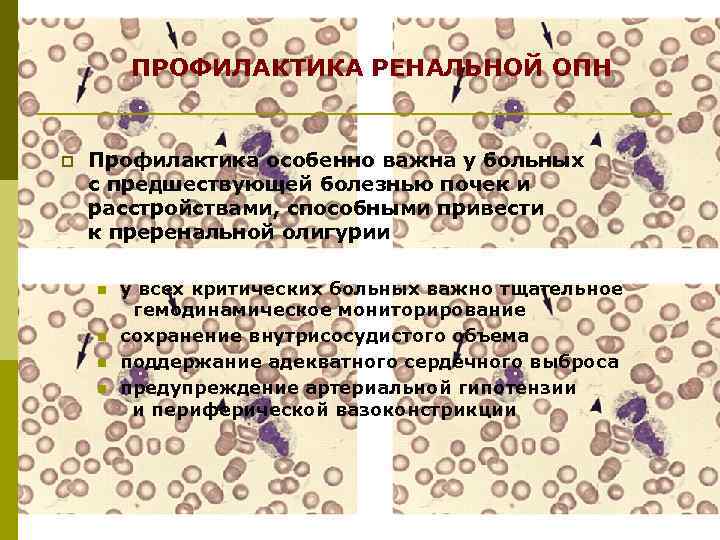
ПРОФИЛАКТИКА РЕНАЛЬНОЙ ОПН p Профилактика особенно важна у больных с предшествующей болезнью почек и
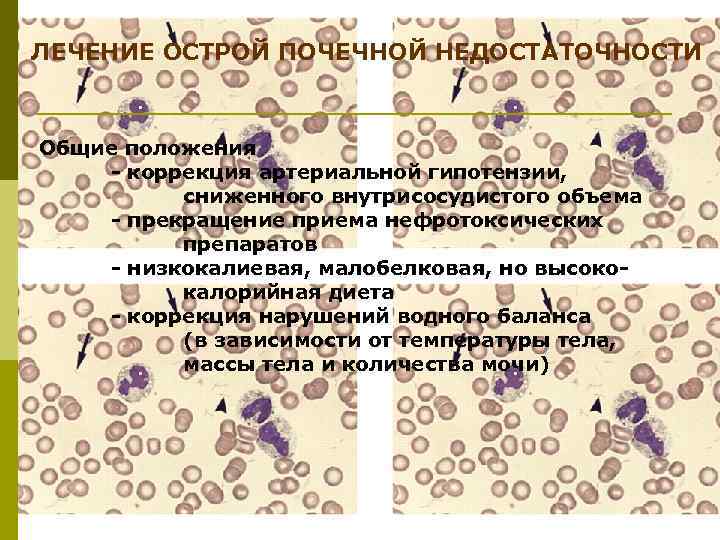
ЛЕЧЕНИЕ ОСТРОЙ ПОЧЕЧНОЙ НЕДОСТАТОЧНОСТИ Общие положения - коррекция артериальной гипотензии, сниженного внутрисосудистого объема -
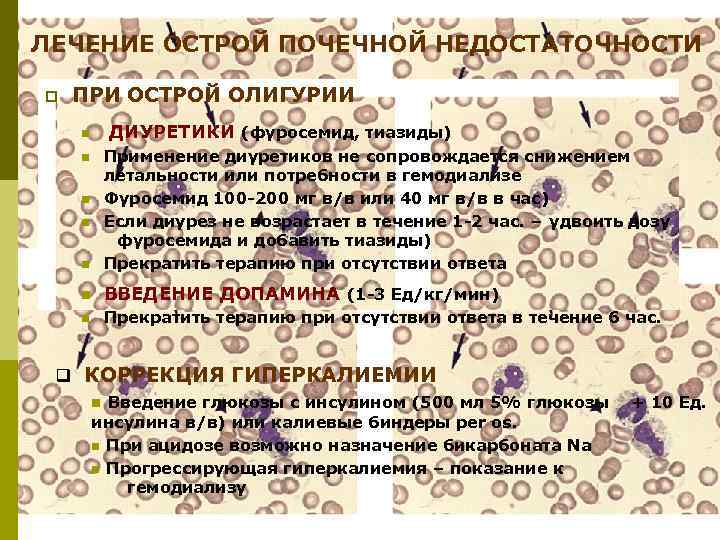
ЛЕЧЕНИЕ ОСТРОЙ ПОЧЕЧНОЙ НЕДОСТАТОЧНОСТИ p ПРИ ОСТРОЙ ОЛИГУРИИ n ДИУРЕТИКИ (фуросемид, тиазиды) Применение диуретиков
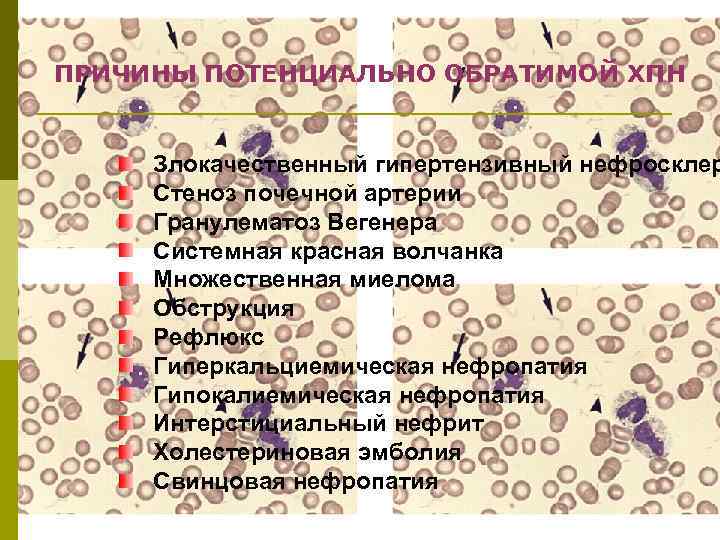
ПРИЧИНЫ ПОТЕНЦИАЛЬНО ОБРАТИМОЙ ХПН Злокачественный гипертензивный нефросклер Стеноз почечной артерии Гранулематоз Вегенера Системная красная
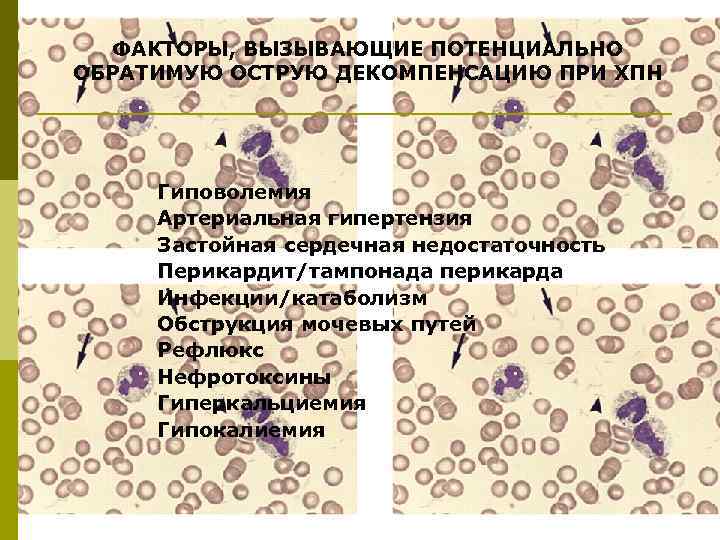
ФАКТОРЫ, ВЫЗЫВАЮЩИЕ ПОТЕНЦИАЛЬНО ОБРАТИМУЮ ОСТРУЮ ДЕКОМПЕНСАЦИЮ ПРИ ХПН Гиповолемия Артериальная гипертензия Застойная сердечная недостаточность
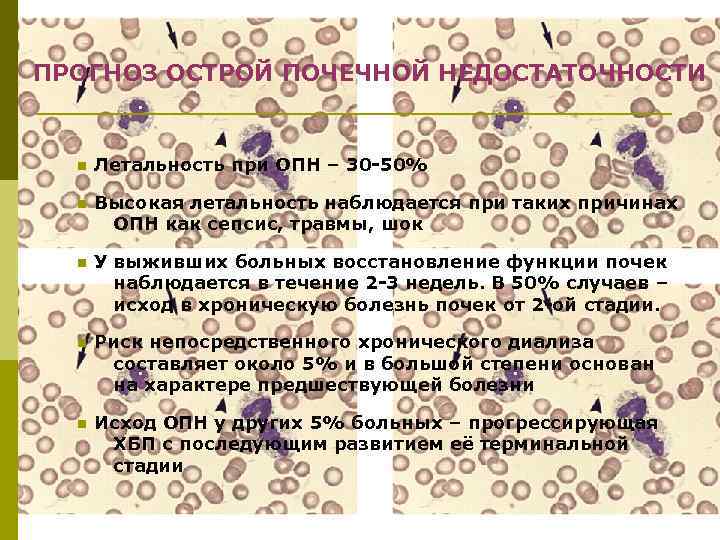
ПРОГНОЗ ОСТРОЙ ПОЧЕЧНОЙ НЕДОСТАТОЧНОСТИ n Летальность при ОПН – 30 -50% n Высокая летальность
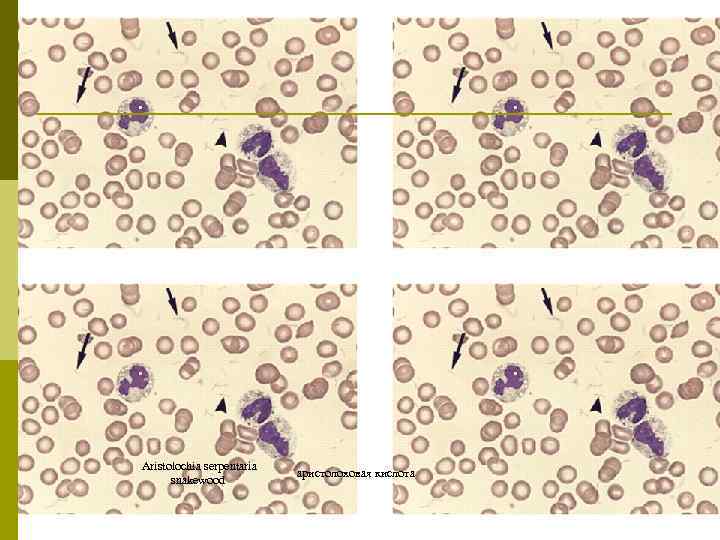
Aristolochia serpentaria snakewood аристолоховая кислота

04 - 2014 О П Н.ppt
- Количество слайдов: 41

ОСТРАЯ ПОЧЕЧНАЯ НЕДОСТАТОЧНОСТЬ С. Боровой, 2014
ОСТРАЯ ПОЧЕЧНАЯ НЕДОСТАТОЧНОСТЬ ОПРЕДЕЛЕНИЕ Внезапное (в течение 48 час. ) снижение функции почек с нарастанием креатинина сыворотки крови на 3 мг/л (≥ 26, 4 μmol/l) или более, увеличением сывороточного креатинина на 50% или более (1, 5 -уровень от исходного), или олигурия – снижение диуреза до уровня менее 0, 5 мл/кг/час в течение не менее 6 часов (Mehta et al, 2007).

ОЛИГУРИЯ и ОПН p Определение: < 400 мл мочи в сутки n часто самый ранний признак почечной дисфункции n крайне важно найти возможные обратимые причины олигурии, которые могут быть ассоциированы с развитием тяжелой степени ОПН и высокой летальностью n ОПН может развиться на фоне не только анурии (< 100 мл/сут) или олигурии, но и полиурии Функциональные нарушения при ОПН n внезапное и тяжелое снижение скорости клубочковой фильтрации n увеличение концентрации в крови мочевины и креатинина n задержка соли и воды n развитие ацидоза и гиперкалиемии

ПАТОФИЗИОЛОГИЯ ОПН, ПОТЕНЦИАЛЬНО ЖИЗНЕННООПАСНЫЕ ОСЛОЖНЕНИЯ ОПН p Нарастание внеклеточного объема (задержка соли и воды) n p отеки, асцит, плевральный выпот, затруднение дыхания, отек легких Гиперкалиемия n n изменения на ЭКГ, аритмии, мышечная слабость или паралич n p нарастание калия сыворотки при анурии – 0, 5 ммоль/л/сут высока при гемолизе, рабдомиолизе, синдроме лизиса опухоли Метаболический ацидоз (отсутствие выведения кислот от метаболизма белков, которые не могут быть выведены с дыханием) n n p дыхание Куссмауля, гипотензия, шок, гиперрефлексия особенно выражен при диабетическом кетоацидозе, лактат-ацидозе, болезнях печени и тканевой ишемии Гиперфосфатемия и гипокальциемия (следствие вторичного гиперпаратиреоидизма) p Полиурия и дизэлектролитемии при восстановлении функции p Анемия (снижение выработки эритропоэтина, гемодилюция, уменьшение длительности жизни эритроцитов, риск кровотечения из-за дисфункции тромбоцитов)

МЕХАНИЗМЫ ОПН p Три варианта n преренальная (сужение внутрисосудистого объема, снижение кардиального выброса или почечного кровотока) n ренальная (болезни крупных почечных сосудов, микрососудистые нефропатии, тубулоинтерстициальные нефриты, острый канальцевый некроз) n постренальная (обструктивная уропатия) Дифференцированное и раннее лечение ОПН предупреждает развитие её с исходом в ХПН
КЛИНИЧЕСКИЕ ПРОЯВЛЕНИЯ ОПН q Во многом обусловлены болезнью или состоянием, приведшими к ОПН. Отдельные варианты имеют характерные симптомы. q Симптомы преренальной ОПН q жажда, снижение тургора кожи, олигурия или анурия, артериальная гипотензия, тахикардия + проявления подлежащего состояния (травма, кардиальные нарушения, дегидратация и др. ) q Симптомы ренальной ОПН q обычно обнаруживается фактор риска ишемии почек или их токсического повреждения q Симптомы постренальной ОПН q боли во фланках или животе, неврологические симптомы q жажда, снижение тургора кожи, олигурия или анурия, артериальная гипотензия, тахикардия
ОСЛОЖНЕНИЯ ОСТРОЙ ПОЧЕЧНОЙ НЕДОСТАТОЧНОСТИ p неврологические n спутанность сознания, сомноленция, судороги p гастро-интестинальные n анорексия, тошнота, рвота, кишечная непроходимость n кровотечения у 10 -30% больных p артериальная гипотензия и шок (инфекции, метаболический ацидоз), кома и смерть (метаболический ацидоз, гиперкалиемия, уремия), отек легких, анемия (сниженный эритропоэз, кровотечения, частые заборы крови), полиурия и дизэлектролитемии

ПРЕРЕНАЛЬНАЯ ОПН p Сердечная недостаточность n p Нарушение почечной ауторегуляции n p инфаркт миокарда, легочная эмболия, застойная сердечная недостаточность, тампонада сердца, искусственная вентиляция расстройства ангиотензин-превращающего фермента Окклюзия почечной артерии или вены n тромбоз, тромбоэмболизм, тяжелый стеноз, расслаивающая аневризма

ПРИЧИНЫ ПРЕРЕНАЛЬНОЙ ОПН Причина Клинические примеры Снижение внеклеточного объема Массивный диурез, кровопотери, диарея и рвота, перемещение внутрисосудистой жидкости во внеклеточное пространство (асцит, перитонит, панкреатит, ожоги), нарушения мембран кожи и слизистых, потери натрия и воды Низкий кардиальный выброс Кардиомиопатии, инфаркт миокарда, тампонада сердца, легочные эмболии, легочная гипертензия, механическая вентиляция легких Снижение системного сосудистого сопротивления Септический шок, печеночная недостаточность, антигипертензивные препараты Высокое сопротивление почечных сосудов Нестероидные противовоспалительные препараты, циклоспорин (neoral, sandimmune), такролимус (prograf), гиперкальциемия, анафилаксия, анестетики, обструкция почечной артерии, тромбоз почечных вен, сепсис, гепаторенальный синдром Снижение тонуса эфферентных артериол Ингибиторы АПФ и блокаторы рецепторов ангиотензина II (снижение СКФ вследствие падения гломерулярного транскапиллярного давления, особенно у больных с двусторонним сужением почечных артерий)
РЕНАЛЬНАЯ ОПН p Васкулит мелких сосудов или острый гломерулонефрит n болезни соединительной ткани (СКВ, склеродерма) n злокачественная гипертензия n токсемия беременности n микроскопический полиартериит n постстрептококковый гломерулонефрит n быстропрогрессирующий гломерулонефрит p Интерстициальный нефрит n лекарства (напр. , метициллин) n инфекции n рак (лимфома, лейкемия, саркоидоз) p Острый канальцевый некроз n ишемия (вторичная к преренальным расстройствам) n нефротоксичные антибиотики (гентамицин, канамицин) n тяжелые металлы (ртуть, цисплатина) n растворители (СCl 4, этиленгликоль) n рентгеноконтрастные препараты n преципитация кристаллов в канальцах (мочевая и щавелевая кислоты) n миоглобинурия

ПРИЧИНЫ РЕНАЛЬНОЙ ОПН Причина Клинические примеры Острое повреждение канальцев Ишемия (длительные или тяжелые преренальные нарушения): хирургические пособия, геморрагии, обструкция артерий или вен, нестероидные противовоспалительные средства, циклоспорин (neoral, sandimmune), такролимус (prograf), амфотерицин (abelcet, ambisome, amphocin, amphotec) Токсины: аминогликозиды амфотерицин В (abelcet, ambisome, amphocin, amphotec), фоскарнет (foscavir), ифосфамид (ifex, mitoxana), метотрексат (rheumatrex), стрептозотоцин, этиленгликоль, гемоглобин (гемоглобинурия), миоглобин (миоглобинурия), тяжелые металлы, радиоконтрастные препараты Острые гломерулопатии ANCA-ассоциированные: гломерулонефрит с полулуниями, узелковый полиартериит, грануломатоз Вегенера Анти-ГБМ гломерулонефрит, синдром Гудпасчера Иммунокомплексные (волчаночный нефрит, криоглобулинемический гломерулонефрит, ОГН) Острый тубулоинтерстициальный нефрит Лекарственный: бета-лактамы, НПВС, сульфаниламиды, ципрофлоксацин (ciloxan, cipro), тиазидные диуретики, фуросемид, циметидин (tagamet), фенитоин (dilantin), аллопуринол (zyloprim), пиелонефрит, папиллярный некроз Острые сосудистые нефропатии Васкулиты, злокачественная артериальная гипертензия, тромботические микроангиопатии, системный склероз, атероэмболизм Инфильтративные Лимфомы, лейкемии, саркоидоз

ПРИЧИНЫ ОПН, АССОЦИИРОВАННЫЕ С ГЛОМЕРУЛОНЕФРОПАТИЯМИ p Первичные системные васкулиты n n n n Гранулематоз Вегенера Микроскопический полиартериит “Идиопатический” нефрит Синдром Чарга-Штрауса Узелковый полиартериит (нечасто) Гигантоклеточный артериит (редко) Болезнь Такаясу (редко) Болезнь кавасаки (очень редко) p p Гломерулонефрит, ассоциированный с инфекцией n n p n n n p Мезангиальная Ig. A-нефропатия Мезангиокапиллярный гломерулонефрит Мембранозная нефропатия С минимальными изменениями Фокальный сегментарный гломерулосклероз Паранеопластический n p Постинфекционный гломерулонефрит Инфекционный эндокардит “Шунтовой” нефрит Другие инфекции (абсцессы и пр. ) “Первичный” гломерулонефрит n Другие системные заболевания Системная красная волчанка n Смешанная эссенциальная криоглобулинемия n Болезнь Шенлейна-Геноха n Болезнь Бехчета n Ревматоидный артрит n Рецидивирующий полихондрит n Системная склеродермия Болезнь Гудпасчера p ассоциированный с карциномой, лимфомой или лейкемией Лекарственный n (OTCN, гидралазин, пеницилламин, 1997) рифампицин

ПОСТРЕНАЛЬНАЯ ОПН p Обструкция верхнего мочевого тракта n p Обструкция нижнего мочевого тракта n p обструкция мочеточника (в одной или обеих почках) интрапузырная или снаружи (чаще) Распознаванию постренальной ОПН помогает УЗИ n n УЗИ почек может обнаружить явный признак обструктивной уропатии - дилатацию мочевого тракта !! дилатация мочевого тракта может отсутствовать при неоплазиях, тяжелой дегидратации, ретроперитонеальном фиброзе, недостаточном времени для её развития

ПРИЧИНЫ ПОСТРЕНАЛЬНОЙ ОПН Причина Закупорка канальцев Обструкция мочеточников Обструкция мочевого пузыря Клинические примеры Мочевая килота (синдром лизиса опухоли), сульфаниламиды, триамтерен (dyrenium), ацикловир (zovirax), индинавир (crixivan), метотрексат (rheumatrex), оксалат Са (отравление этиленгликолем), миеломные белки, миоглобин Изнутри: камни, кровяные сгустки, слущенная почечная ткань, микотические сгустки, отек, опухоли, врожденные дефекты Снаружи: опухоли, ретроперитонеальный фиброз, повреждение мочеточника (при оперативных пособиях или тяжелых травмах) Механическая: гипертрофия предстательной железы, Са простаты, рак мочевого пузыря, стриктуры или складки уретры, фимоз, парафимоз, обструкция постоянным мочевым катетером
ДИАГНОЗ ОСТРОЙ ПОЧЕЧНОЙ НЕДОСТАТОЧНОСТИ Анамнез Исследование мочи - мочевой осадок - посев мочи - 24 -час. моча Лабораторные тесты Ультразвуковое исследование Абдоминальная компьютерная томография Нефробиопсия
АНАМНЕЗ БОЛЬНОГО С ОПН p Основная цель – дифференцировать ОПН, развившуюся на фоне хронической болезни почек с ОПН без наличия предшествующей болезни почек p Предшествующие болезни почек, наличие или признаки системных заболеваний p Лекарственные препараты (антибиотики, диуретики, другие нефротоксины) p Эпизоды гиповолемии p Перенесенные оперативные вмешательства (анестезия, объем операции, реанимационные пособия) p Неплохо проведенный отпуск

Диагностика ОПН. Исследование мочи Мочевой осадок «Пустой» осадок мочи указывает на преренальную или постренальную ОПН. При преренальной ОПН могут обнаруживаться гиалиновые и зернистые цилиндры. Мочевые цилиндры с эритроцитами характерны для гломерулонефрит, а с гранулоцитами - для канальцевого некроза. При ренальной ОПН в 80% случаев находят канальцевые эпителиальные клетки (простые или в цилиндрах). Лейкоцитурия указывает на интерстициальный нефрит или пиелонефрит. Кристаллы мочевой кислоты могут наблюдаться при синдроме лизиса опухоли. Посев мочи Обнаруживает бактериурию и идентифицирует её. 24 -час. моча В суточной порции мочи измеряются следующие параметры: креатинин, электролиты, белок, осмоляльность и р. Н. Экскреция натрия различна при преренальной и ренальной ОПН. При канальцевой дисфункции натрий не реабсорбируется и концентрация его в моче высокая. Концентрация натрия в моче менее 10 ммоль/л характерна для преренальной ОПН. Фракционная экскреция натрия (Fe. Na) определяет его выведение в соответствии с выведением креатинина. Fe. Na менее 1 предполагает ренальную ОПН, а более 1 – преренальную ОПН. Fe. Na = UNa × PCr PNa × PCr

Диагностика ОПН. Мочевые индексы – дифференцирование пре- и постренальной ОПН Индекс Преренальная Постренальная ОПН Na мочи (м. М/л) <20 >40 Фракционная экскреция Na+ <1 >1 Креатинин U/P >40 <20 Осмолярность U/P >1. 5 <1. 1 !! Использование мочевых индексов предполагает, что способность почек реабсорбировать натрий и воду не нарушается при преренальной ОПН n образцы мочи и крови должны быть взяты до введения жидкости, диуретиков, маннитола и др. n моча не должна содержать глюкозу или рентгеноконтрастные препараты n острый канальцевый некроз при миоглобинурии или рентгеноконтрастных препаратах может иметь Fe. Na < 1%
Диагностика ОПН. Лабораторные тесты Клинический анализ крови Электролиты крови и мочи Газовый анализ крови Посев крови Показатели свертываемости крови Сыворотка крови: креатинин, мочевина, мочевая кислота, ЛДГ, креатинкиназа, липаза, печеночные ферменты Общий белок и альбумин плазмы, иммуноглобулины (электрофорез протеинов), С-реактивный белок
Диагностика ОПН. Лучевые методы исследования Ультразвуковое исследование Устанавливает размеры почек, может определить почечный кровоток и индекс резистивности. Важно для исключения обструктивной уропатии и задержки мочи. Исследование органов брюшной полости необходимо для обнаружения возможной их патологии. Абдоминальная компьютерная томография (без контрастных агентов!) Может применяться для исключения постренальной ОПН, если подозрения на неё сохраняются и после ультразвукового исследования.

Диагностика ОПН. Показания к диагностической нефробиопсии q Отсутствие очевидной причины ОПН q Тяжелая олигурия или анурия длительностью более 2 -3 недель q Внепочечные проявления более диффузной болезни, напр. , такой как васкулит q Исключение возможного острого интерстициального нефрита у больных, нуждающихся в продолжении лечения потенциально нефротоксическим препаратом Faber M. D. et al. The differential diagnosis of acute renal failure. In: Acute Renal Failure / Ed. by M. J. Lazarus, B. M. Brenner. - 3 rd Ed. , 1993 q ОПН с нефритическим мочевым осадком (микрогематурия, деформированные эритроциты, эритроцитарные цилиндры, протеинурия) q ОПН без очевидной причины, не разрешающаяся в течение 2 -х недель
ПРОФИЛАКТИКА РЕНАЛЬНОЙ ОПН p Профилактика особенно важна у больных с предшествующей болезнью почек и расстройствами, способными привести к преренальной олигурии n n у всех критических больных важно тщательное гемодинамическое мониторирование сохранение внутрисосудистого объема поддержание адекватного сердечного выброса предупреждение артериальной гипотензии и периферической вазоконстрикции

ПРОФИЛАКТИКА ГОСПИТАЛЬНОЙ ОПН p Наиболее эффективный способ адекватная коррекция внеклеточного объема. p Маннитол и петлевые диуретики могут увеличить диурез, что облегчает лечение больного с ОПН.
ЛЕЧЕНИЕ ОСТРОЙ ПОЧЕЧНОЙ НЕДОСТАТОЧНОСТИ Общие положения - коррекция артериальной гипотензии, сниженного внутрисосудистого объема - прекращение приема нефротоксических препаратов - низкокалиевая, малобелковая, но высококалорийная диета - коррекция нарушений водного баланса (в зависимости от температуры тела, массы тела и количества мочи)
ЛЕЧЕНИЕ ОСТРОЙ ПОЧЕЧНОЙ НЕДОСТАТОЧНОСТИ p ПРИ ОСТРОЙ ОЛИГУРИИ n ДИУРЕТИКИ (фуросемид, тиазиды) Применение диуретиков не сопровождается снижением летальности или потребности в гемодиализе Фуросемид 100 -200 мг в/в или 40 мг в/в в час) Если диурез не возрастает в течение 1 -2 час. – удвоить дозу фуросемида и добавить тиазиды) Прекратить терапию при отсутствии ответа n ВВЕДЕНИЕ ДОПАМИНА (1 -3 Ед/кг/мин) n Прекратить терапию при отсутствии ответа в течение 6 час. n n q КОРРЕКЦИЯ ГИПЕРКАЛИЕМИИ n Введение глюкозы с инсулином (500 мл 5% глюкозы + 10 Ед. инсулина в/в) или калиевые биндеры рer os. n При ацидозе возможно назначение бикарбоната Na n Прогрессирующая гиперкалиемия – показание к гемодиализу

ЛЕЧЕНИЕ ОСТРОЙ ПОЧЕЧНОЙ НЕДОСТАТОЧНОСТИ q ЗАМЕСТИТЕЛЬНАЯ ПОЧЕЧНАЯ ТЕРАПИЯ q Показания к диализу: гиперкалиеми >6. 5 ммоль/л, тяжелый метаболический ацидоз, отек легких, мочевина сыворотки крови >200 мг%l, симптомы уремии (перикардит, неврологические и др. ) q Гемодиализ или гемофильтрация: методы выбора для лечения ОПН у взрослых q Перитонеальный диализ применяется при лечении новорожденных и молодых детей q ДИЕТА q Протеиновый катаболизм при ОПН может достигать 200 -250 г/сут. q Отрицательный азотистый баланс приводит к истощению, снижению иммунного ответа, увеличивает риск неблагоприятного (в том числе летального) исхода q Агрессивная диета должна назначаться рано

Влияет ли олигурия на потребность больных ОПН в диализе? p Kleinknecht et al. (1976) 66 больных, плацебо или фуросемид p Brown, Ogg and Cameron (1981) 58 больных, 1 г фуросемида, далее без диуретиков, или с ними В обоих исследованиях не нашли различий между двумя группами больных в отношении потребности в диализе, длительности диализа, а также летальности и выживаемости

ДИФФУЗНЫЕ НЕФРОПАТИИ В ДИФФЕРЕНЦИАЛЬНОМ ДИАГНОЗЕ ОПН p p p Экстракапиллярный гломерулонефрит Нефротический синдром с минимальными изменениями Интерстициальный нефрит Узелковый полиартериит Гранулематоз Вегенера Амилоидоз Множественная миелома Эндокапиллярный пролиферативный гломерулонефрит Кортикальный некроз Гемолитико-уремический синдром Системная красная волчанка Тромботическая тромбоцитопеническая пурпура
ПРИЧИНЫ ПОТЕНЦИАЛЬНО ОБРАТИМОЙ ХПН Злокачественный гипертензивный нефросклер Стеноз почечной артерии Гранулематоз Вегенера Системная красная волчанка Множественная миелома Обструкция Рефлюкс Гиперкальциемическая нефропатия Гипокалиемическая нефропатия Интерстициальный нефрит Холестериновая эмболия Свинцовая нефропатия
ФАКТОРЫ, ВЫЗЫВАЮЩИЕ ПОТЕНЦИАЛЬНО ОБРАТИМУЮ ОСТРУЮ ДЕКОМПЕНСАЦИЮ ПРИ ХПН Гиповолемия Артериальная гипертензия Застойная сердечная недостаточность Перикардит/тампонада перикарда Инфекции/катаболизм Обструкция мочевых путей Рефлюкс Нефротоксины Гиперкальциемия Гипокалиемия
ПРОГНОЗ ОСТРОЙ ПОЧЕЧНОЙ НЕДОСТАТОЧНОСТИ n Летальность при ОПН – 30 -50% n Высокая летальность наблюдается при таких причинах ОПН как сепсис, травмы, шок n У выживших больных восстановление функции почек наблюдается в течение 2 -3 недель. В 50% случаев – исход в хроническую болезнь почек от 2 -ой стадии. n Риск непосредственного хронического диализа составляет около 5% и в большой степени основан на характере предшествующей болезни n Исход ОПН у других 5% больных – прогрессирующая ХБП с последующим развитием её терминальной стадии

Редкие причины ОПН

Нефропатия, вызванная Сapnocytophaga canimorsus p Capnocytophaga canimorsus – Грам– бактерия, комменсал слюны собак и кошек. Заражение происходит при укусе, лизании открытых ран и царапин. p Клинические проявления неспецифичны: n лихорадка, озноб, боль в животе, диарея, рвота n эритема или макуло-папулярная сыпь n лейкоцитоз, ДВС-синдром, почечная недостаточность, ГУС p Capnocytophaga canimorsus чувствительна к пенициллинам, цефалоспоринам, левомицетину, клиндамицину. p Функция почек восстанавливается не всегда, летальность высокая.

Больной 41 года, с двухдневной историей болей в животе, диареи, лихорадкой под 40 град. Hb 94 г/л, лейкоцитов 11700. тромбоцитов 1000 в куб. мм. В мазке крови – бактерии, идентифицированные как Capnocytophaga canimorsus.

Дифференцирование укуса человека и собаки А Б

Нефропатия, вызванная «волшебными грибочками» Отравление грибами Cortinarius speciosissimus (= Cortinarius rubellus, Cortianarius orellanoides) приводит к ОПН, которая необратима более чем у половины больных. Такие случаи зарегистрированы в Польше, Финляндии, Шотландии, Швеции, Норвегии, Франции. Вне Европы – в Канаде. Морфология: почки увеличены в размере, клубочки не изменены, выраженный интерстициальный отек, канальцы заполнены белковым содержимым, иммунофлуоресценция отрицательна.

«Волшебные грибочки» Psilocybe semilanceata Грибы вида Cortinarius orellanoides

Cortinarius speciosissimus (= Cortinarius rubellus, Cortianarius orellanoides)

Нефропатия, вызванная китайскими травами p Первые случаи в Европе описаны в 1993 г. у женщин, принимавших сборы китайских трав для похудания p Клинические проявления: быстрая необратимая почечная недостаточность p Морфология: интерстициальный фиброз p Специализированная клиника: госпиталь Святого Луки в Брюсселе p Причинные агенты: аристолоховая кислота (1994 г. ), НПВС, тяжелые металлы, иммунные эффекты p Токсичны многие сборы китайских трав (для лечения ожирения, дисменореи, ослабленной мужской потенции), как на почки, так и на уротелий (онкогенный), печень, сердечные клапаны, легкие
Aristolochia serpentaria snakewood аристолоховая кислота

04 - 2014 О П Н.ppt